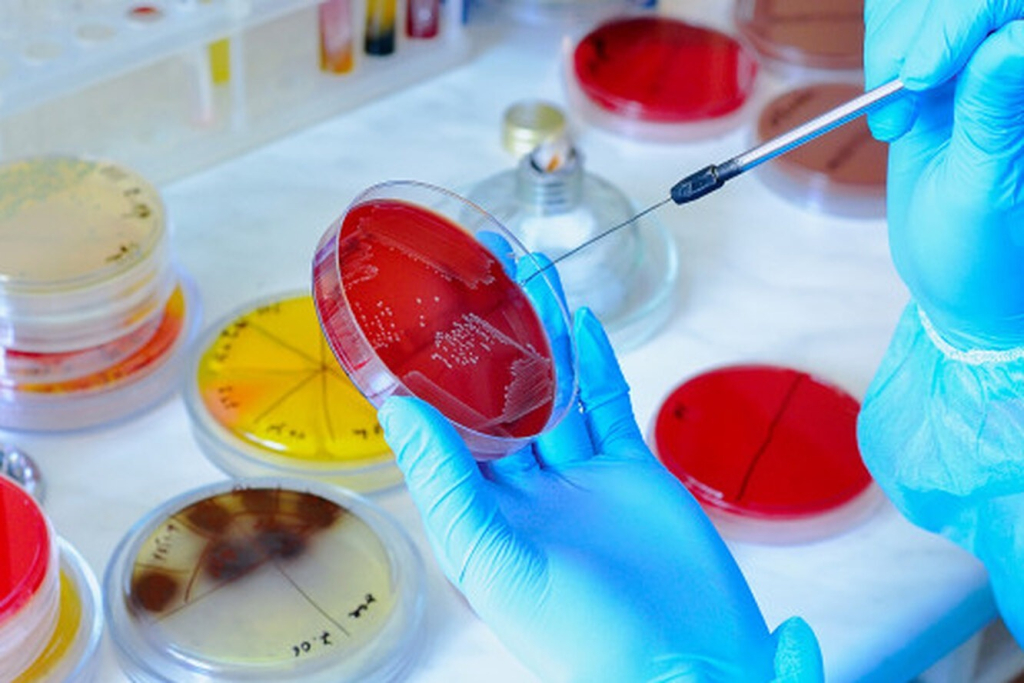

AnGuzal Agroservis на INNOweek2023
AnGuzal Agroservis на INNOweek2023
В середине октября, в Агентстве Инновационного Развития состоялась неделя Инновационных Идей "INNOweek2023". Основная цель мероприятия - продемонстрировать новые отечественные и зарубежные технологии, повысить уровень жизни населения и привлечь новые инвестиционные возможности, выгодные для экономики страны, за счет обмена новыми технологиями.
Международная Конференция была посвящена теме "Трансформации и Тенденции Развития Химической и Газохимической Отрасли на Основе Научных Подходов". В конференции принимали участие представители бизнеса, науки и технологий, как из нашей Республики, так и зарубежные эксперты из России , Германии, Британии, Индии и других стран.
На конференции, были представлены инновационные разработки в различных отраслях химической, биологической и фармацевтической промышленности, были обсуждены острые современные проблемы и методы их решения.
Международная конференция
В рамках мероприятия "INNOweek2023" наша компания приняла активное участие, в лице основателя и директора ООО "AnGuzal Agroservis" Гузаловой Анаиды Георгиевны.

Гузалова Анаида Георгиевна
Нашей Компанией были представлены новейшие разработки для Сельскохозяйственной сферы.
На сегодняшний день остро стоит вопрос применения минеральных удобрений, которые активно применяются в Традиционном сельском хозяйстве. С их помощью развивается интенсивное возделывание технических и продовольственных культур, однако так же, большая часть минеральных удобрений вносимых в почву, переходит в нерастворимую или труднодоступную форму, испаряется или вымывается с поливом, отчего требуется все большее количество данных удобрений. Помимо этого патогенные микроорганизмы, такие как представители рода Fusarium, Alternarium и другие способны использовать компоненты минеральных удобрений для собственного роста и размножения, тем самым нанося урон посевам.

Получение урожая
В ходе наших исследований и проведенных опытов совместно с АО "Uzkimyosanoat" и АО "MAXAM-CHIRCHIQ" мы разработали Уникальную Схему для повышения эффективности применения Минеральных Удобрений, которая позволяет повысить их усвоение, тем самым меньше засоляя почву, снижая число патогенных микроорганизмов и повышения корневого питания для растений.
Повышение усвоения удобрений
Долгие годы наша организация проводит исследования и поиски высокоэффективных штаммов микроорганизмов, на территории нашей страны с целью получения качественных препаратов и облегчения работы фермеров.
Основные исследования проводились с системной бактерией, обладающей фунгицидными свойствами Bacillus Subtilis, которая способна синтезировать около 24 антибиотиков для защиты растений от патогенных микроорганизмов. Это уникальная бактерия, которая широко применяется в мире не только в растениеводстве, но и в животноводстве и фармацевтике.
Наша компания провела множественные лабораторные и полевые испытания и получила заключения от нескольких компаний - партнеров, выявив следующие позитивные изменения в области сельского хозяйства при применении нашей Уникальной Схемы, а именно:
- Повысить усвояемость минеральных удобрений от 10% до 40%
- Ускорить рост и развитие растений на 20%
- Увеличить урожай до 50%
- Противодействовать выносу минеральных удобрений из почвы;
- Защищать растения от фитопатогенных микроорганизмов;
Так же Наша Схема позволяет фермерам экономить средства за счёт сокращения применения большого количества удобрений и пестицидов, антистрессантов и является абсолютно безопасной для человека и окружающей среды.

Экономическая выгода
Компания ООО AnGuzal Agroservis является первым на территории Республики Узбекистан производителем микробиологических препаратов и уже на протяжении 15 лет способствует развитию безопасного и высокоэффективного возделывания сельскохозяйственных культур. Широкая линейка производимых препаратов и современная, оснащенная необходимым оборудованием микробиологическая лаборатория позволяют найти индивидуальный подход к каждому клиенту, выявить проблемы и найти лучшее решение для получения большого урожая высокого качества.
Микробиологическая лаборатория
"INNOweek2023" дала возможность нашей организации выступить и представить наши исследования которые в дальнейшем смогут помочь вывести сельское хозяйство на новый уровень, внести свой вклад в развитие экономики, внедрить новые технологии в сельскохозяйственную отрасль.
Для подробного ознакомления с нашей Схемой можете обращаться по номерам:
Телеграм:
https://t.me/AnguzalAgroservis_guruhi
https://t.me/anguzal_agroservis
Инстаграм:


//= get_field('image') ?>